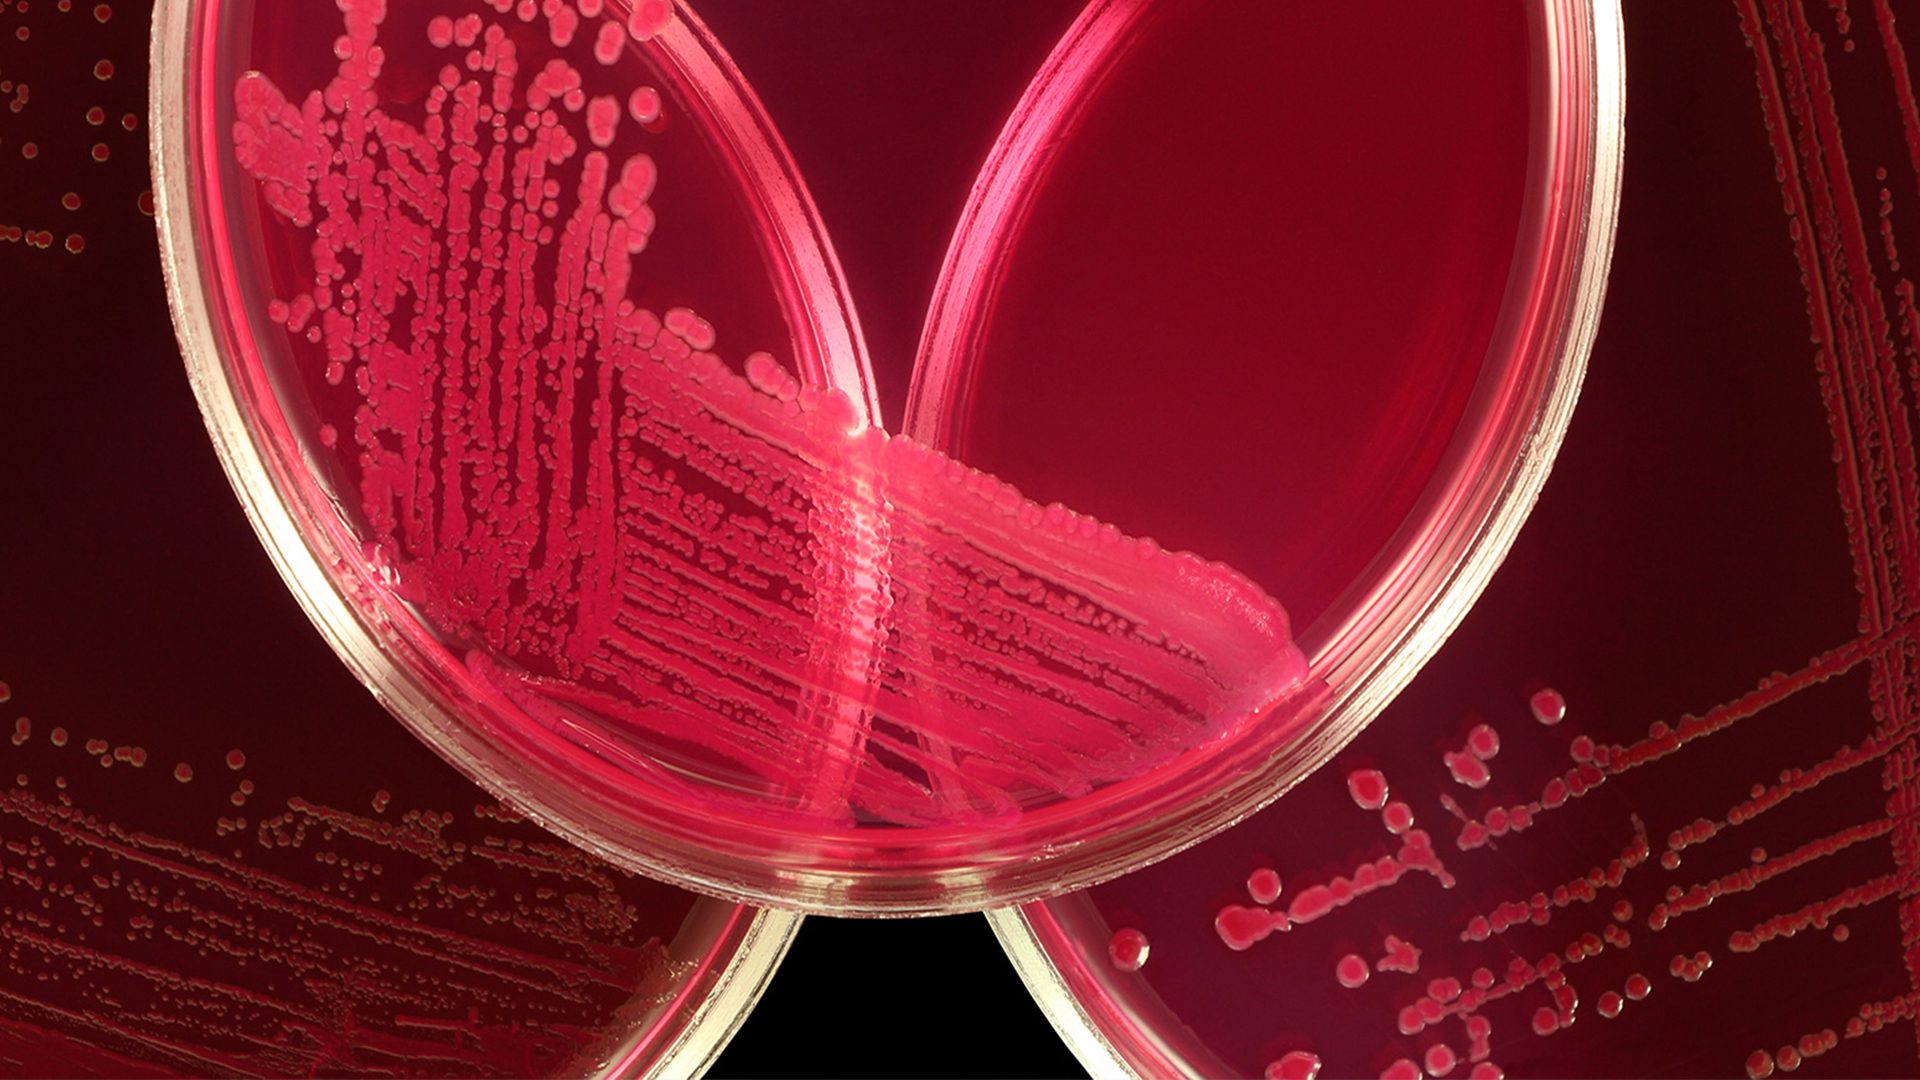
Close up of test samples in container under red light

At the Curtin Medical Research Institute (Curtin MRI), researchers, doctors, nutritionists and pharmaceutical scientists are advancing new treatments for major chronic diseases including Alzheimer’s disease, inflammatory disorders, heart disease and traumatic brain injuries. Cancer is a key focus, with Curtin a founding co-leader in the A$10.8 million Liver Cancer Research Centre.
Professor Oliver Rackham: Gene Therapy to Treat Childhood Genetic Disorders
Professor Oliver Rackham, a researcher at Curtin Medical School, is pioneering gene therapy innovations to treat childhood genetic disorders. His team has developed artificial proteins that seek out and correct faulty genes – an exciting breakthrough with real clinical applications.
Our strengths
Cancer
We’re researching interventions for age-associated cancers such as breast, pancreas and prostate cancer and melanoma, with a focus on how the immune system influences cancer risk and disease progression.
In addition, scientists in Curtin MRI’s Liver Cancer Research Centre are investigating how liver cells ‘talk’ to each other and stopping them from becoming cancerous. We aim to give oncologists more precision to create personalised treatment plans, matching each patient with a medication that targets specific tumour types.
Learn more:
Clinical research
We’re investigating ways to improve patient outcomes in a broad range of clinical areas, diseases and medical conditions, including maternal and children’s health, paediatric critical and intensive care, mental health, rural health, chronic disease management and pre-hospital emergency care.
This work has led to the development of a new paediatric early warning system for recognising and responding to paediatric clinical deterioration: the ESCALATION Project. Tested at multiple sites across WA, this system is now fully implemented at Perth Children’s Hospital and Broome Hospital, with implementation at other sites across WA planned.
Learn more:
Inflammation and infectious disease
In this space, we are developing ways to stop the decline in immune system function with ageing, using the immune system itself to treat arthritis and adult cancers. We’re improving immune function for the treatment of infection and muscle repair, and working with the Telethon Kids Institute on global malaria epidemiology.
We’re also working to improve clinical practice and healthcare outcomes in the area of wound healing, which often affects the elderly. Our research has provided a rich source of data and made significant economic and therapeutic impacts on skin tear prevention and management.
Learn more:
Neurodegenerative disorders
Researchers are exploring new approaches for the prevention and treatment of Alzheimer’s disease, where we’re hoping to significantly slow cognitive decline. We’re also mapping the journey of brain injury patients, from incident to integration back into the community, and taking a world-first approach to attenuate the burden associated with chronic migraine.
Learn more:
Vascular and metabolic disorders
Scientists at Curtin MRI are identifying new treatments for blood vessel disorders including bleeding and clotting disorders, heart disease and stroke, and investigating blood vessel growth and function to treat age-associated cancers, blood-vessel inflammatory disorders, energy disorders, liver disorders and infectious diseases.
One example is a collaborative team of bio-nanotechnology and drug development researchers within Curtin MRI who are identifying new therapies and drug delivery methods for the treatment of diabetes and other age-related diseases. The team uses nano-micro encapsulation technology to design innovative formulations capable of delivering drugs or pancreatic cells to treat diabetic patients.
Learn more:

Looking for a researcher?
Where we work

Curtin Medical Research Institute
MRI’s research spans cancer, inflammation, infectious disease and wounds, neurodegenerative disorders and vascular and metabolic disorders.
Learn more
Curtin Medical School
Curtin Medical School brings together expertise in the fields of biomedical sciences, laboratory medicine, pharmacy, medical radiation science and medicine.
Learn more
School of Molecular and Life Sciences
Our research spans agribusiness and agricultural science, environmental biology and marine science including hydrodynamics, sonar imaging and marine bioacoustics.
Learn morePartner with us
By partnering with Curtin, you’ll gain access to a network of experts and specialised facilities that can help your business become more efficient, sustainable and profitable. There are also opportunities for investment, licensing, mentoring and employment.
Reach out to Curtin’s Research Partnerships Team using the form below.